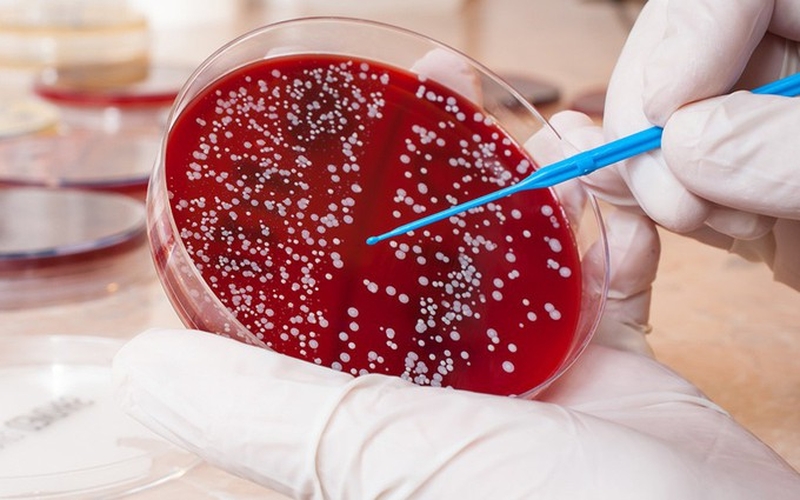
U nguyên bào thần kinh ở trẻ em có điều trị được không? 4

Tốt nghiệp Khoa Dược trường Đại học Võ Trường Toản. Có nhiều năm kinh nghiệm trong ngành Dược. Hiện đang là giảng viên cho Dược sĩ tại Nhà thuốc Long Châu.
U nguyên bào thần kinh ở trẻ em có điều trị được không?
20/07/2023
Mặc định
Lớn hơn
U nguyên bào thần kinh là một trong những căn bệnh hiếm gặp ở trẻ em. Nhiều bậc cha mẹ phân vân rằng liệu u nguyên bào thần kinh ở trẻ em có chữa được không? Bằng phương pháp nào?
Trẻ em mắc bệnh u nguyên bào thần kinh thường cảm thấy buồn nôn, đau bụng, chán ăn, mệt mỏi và sút cân. Trong khi đó, trẻ rất nhạy cảm với bất cứ phương pháp điều trị và các loại thuốc được đưa vào cơ thể nên các bác sĩ cần thử nghiệm lâm sàng trước khi quyết định chữa trị bằng bất cứ phương pháp nào. Bằng sự phát triển của y học, có những phương pháp chữa u nguyên bào thần kinh phổ biến sau:
Nguyên tắc lựa chọn điều trị
Các phương pháp này cũng không cố định mà sẽ biến đổi phụ thuộc vào nhóm tiên lượng nặng. Bên cạnh việc điều trị các triệu chứng bệnh, cải thiện các tác dụng phụ cũng là điều vô cùng quan trọng trong quá trình điều trị.
Việc lựa chọn phương pháp điều trị sẽ phụ thuộc vào nhiều yếu tố:
- Kích thước, vị trí khối u.
- Sự di căn của khối u.
- Phân loại nguy cơ.
- Tác dụng phụ có thể xảy ra.
- Lựa chọn của gia đình.
- Sức khỏe của trẻ.
 Các bác sĩ cần tuân thủ tuyệt đối nguyên tắc điều trị
Các bác sĩ cần tuân thủ tuyệt đối nguyên tắc điều trị Các phương pháp điều trị phổ biến
Cha mẹ hãy dành thời gian tìm hiểu về các phương pháp chữa trị này để hiểu hơn về căn bệnh của con. Đồng thời, có kế hoạch dài hạn cho việc chăm sóc và theo dõi quá trình điều trị của con.
Theo dõi
Với những trẻ có khối u nhỏ hoặc u ác tính mọc ở những vị trí không thể phẫu thuật, các bác sĩ sẽ tiến hành theo dõi. Điều này là rất phổ biến với những bệnh nhi dưới 6 tháng tuổi và mắc khối u khu trú với kích thước nhỏ. Các chuyên gia sẽ theo dõi sát bằng các phương tiện chẩn đoán hình ảnh, khám xét kỹ các triệu chứng và các xét nghiệm cận lâm sàng.
Trong một số trường hợp, khối u sẽ tự tiêu biến mà không cần điều trị. Tuy nhiên, với những khối u tiến triển không ngừng, hóa trị liệu sẽ được áp dụng, việc chỉ định phẫu thuật đi kèm có thể được đặt ra.
Phẫu thuật
Phẫu thuật được tiến hành với mục đích cắt bỏ khối u. Cha mẹ cần chấp nhận rằng trong quá trình phẫu thuật, bác sĩ bắt buộc phải cắt thêm một ít mô lành xung quanh để đảm loại bỏ hoàn toàn khối u. Nếu các tế bào ung thư không lan rộng, các phẫu thuật viên có thể cắt toàn bộ khối u. Tuy nhiên, hầu hết u nguyên bào thần kinh được tìm thấy khi chúng đã lan rộng. Trong trường hợp này, phẫu thuật viên sẽ cắt bỏ khối u nhiều nhất có thể.
 Phẫu thuật là phương pháp điều trị u nguyên bào thần kinh phổ biến
Phẫu thuật là phương pháp điều trị u nguyên bào thần kinh phổ biến Hóa trị
Hóa trị là phương pháp dùng thuốc phá hủy các tế bào ung thư, ngăn cản quá trình phát triển và phân chia của khối u. Thuốc hóa trị sẽ được đưa vào cơ thể, đi vào máu đến các tế bào của cơ thể. Thông thường , hóa trị thường đi qua đường truyền tĩnh mạch bằng kim hoặc dùng thuốc hoặc viên con nhộng bằng đường uống. Lịch vô thuốc thường được sắp xếp trong một khoảng thời gian nhất định.
Đa số các bệnh nhi bị u nguyên bào thần kinh đều sẽ cần hóa trị. Đây có thể là phương pháp điều trị đầu tiên dành cho bệnh này. Hoặc nó sẽ được áp dụng trước khi phẫu thuật để làm co nhỏ khối u hoặc sau phẫu thuật để tiêu diệt các tế bào ung thư còn sót lại.
Bệnh nhi thuộc nhóm nguy cơ trung bình thường sẽ được cho các thuốc sau:
- Carboplatin (paraplatin).
- Cyclophosphamide (neosar).
- Doxorubicin (adriamycin).
- Etoposide.
Bệnh nhi thuộc nhóm nguy cơ cao thường sẽ được cho các thuốc sau:
- Busulfan (busulfex, myleran).
- Carboplatin (paraplatin).
- Cisplatin (platinol).
- Cyclophosphamide (neosar).
- Cytokines (gm-csf and il2).
- Dinutuximab (unituxin).
- Doxorubicin (adriamycin, doxil).
- Etoposide (vepesid, toposar).
- Ifosfamide (ifex).
- Isotretinoin.
- Melphalan (alkeran).
- Thiotepa.
- Topotecan (hycamtin).
- Vincristine (vincasar).
Tác dụng phụ của hóa trị phụ thuộc vào từng cá nhân và liều dùng thuốc, nhưng bệnh nhi có thể sẽ có các triệu chứng như: Mệt mỏi, nguy cơ nhiễm trùng cao, nôn, buồn nôn, rụng tóc, mất cảm giác thèm ăn, tiêu chảy. Các tác dụng phụ thường sẽ biến mất khi quá trình điều trị kết thúc. Độ nặng của tác dụng phụ phụ thuộc vào loại và hàm lượng thuốc được cho cũng như khoảng thời gian mà bệnh nhân vô thuốc.
 Hầu hết các bệnh nhi mắc u nguyên bào thần kinh đều trải qua hóa trị
Hầu hết các bệnh nhi mắc u nguyên bào thần kinh đều trải qua hóa trị Xạ trị
Xạ trị là phương pháp dùng tia X năng lượng cao hoặc các thành phần khác để phá hủy tế bào ung thư. Dạng xạ trị phổ biến nhất là xạ trị ngoài, đây là phương pháp xạ trị chiếu tia từ một máy bên ngoài cơ thể.
Chế độ điều trị xạ trị được sắp xếp trong một khoảng thời gian. Tác dụng phụ của xạ trị bao gồm: Mệt mỏi, nhạy cảm da nhẹ, rối loạn tiêu hóa, giảm nhu động ruột. Đa số các tác dụng phụ sẽ biến mất khi kết thúc quá trình điều trị.
Do xạ trị thỉnh thoảng có thể ảnh hưởng đến sự phát triển của não trẻ, buồng trứng ở trẻ gái và tinh hoàn ở bé trai, các bác sĩ có thể lựa chọn điều trị ung thư theo một hướng khác.
Ghép tủy xương/ ghép tế bào gốc
Ghép tủy xương là một phương pháp trong y khoa mà các bệnh lý tủy xương được thay thế bằng các tế bào đặc biệt, được gọi là tế bào gốc tạo máu. Có 2 loại ghép tế bào gốc phụ thuộc vào nguồn thay tế bào tạo máu: Ghép tự thân hoặc ghép đồng loại. Ghép tự thân thường được dùng cho các bệnh nhi có u nguyên bào thần kinh nguy cơ cao.
Mục tiêu của việc ghép là phá hủy các tế bào ung thư trong tủy xương, máu, và các cơ quan khác trong cơ thể vào cho phép tế bào máu thay thế tạo ra một tủy xương khỏe hơn. Trong hầu hết các trường hợp ghép tế bào gốc, bệnh nhi được điều trị với liều hóa trị cao có thể kèm theo hoặc không xạ trị để phá hủy các tế bào ung thư trong mức có thể.
Ghép tủy đòi hỏi kỹ thuật hiện đại
Ghép tủy đòi hỏi kỹ thuật hiện đại Liệu pháp Retinoid
Retinoid là một hoạt chất tương tự như vitamin A. Các nhà nghiên cứu cho rằng chúng có tác dụng giúp các tế bào trưởng thành thành các tế bào bình thường.
Liệu pháp miễn dịch
Liệu pháp miễn dịch được áp dụng để nâng cao khả năng miễn dịch của cơ thể chống lại ung thư. Có thể phối hợp cả hai hoặc một trong 2 loại: Từ cơ thể hoặc từ phòng thí nghiệm để nâng đỡ, cải thiện hệ thống miễn dịch.
Điều trị trúng đích bằng Nuclit phóng xạ
Nuclit phóng xạ là MIBG được dùng để điều trị các bệnh nhi bị u nguyên bào thần kinh tái phát, và có khoảng 30% trường hợp đáp ứng điều trị.
 Nuclit phóng xạ là phương pháp mới trong điều trị u nguyên bào thần kinh
Nuclit phóng xạ là phương pháp mới trong điều trị u nguyên bào thần kinhTrên đây là những phương pháp điều trị u nguyên bào thần kinh ở trẻ em. Nếu được điều trị trong giai đoạn đầu cùng với sự chăm sóc cẩn thận, trẻ hoàn toàn có thể chiến thắng được căn bệnh này.
Thu Trang
Nguồn: Yhoccongdong.com
Các bài viết liên quan
Uống thuốc phóng xạ thì bao lâu mới được quan hệ?
Phát hiện mới về hệ miễn dịch có thể giúp chống lại tế bào ung thư
Thực đơn cho người ung thư phổi giai đoạn cuối giúp cải thiện thể trạng
Các triệu chứng ung thư dạ dày giai đoạn đầu thường gặp
Ung thư phổi di căn xương và những điều cần biết
Tại sao nốt ruồi ngày càng to ra? Dấu hiệu cảnh báo cần lưu ý
Bác sĩ cảnh báo 6 thói quen tiết kiệm có thể "rước" ung thư
Các loại virus gây ung thư thường gặp và cách phòng ngừa hiệu quả
Ăn cay nhiều có gây ung thư không? Giải đáp chi tiết và khoa học
Dấu hiệu ung thư tủy xương giai đoạn sớm mà người bệnh không nên chủ quan
:format(webp)/Option_1_2_2d9677e5fd.png)
:format(webp)/Option_1_1_2a84e0cd00.png)
:format(webp)/ds_khanh_tuong_1_592bf2eb07.png)